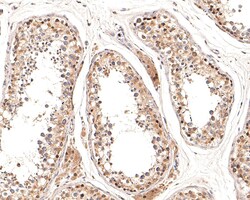
Invitrogen ATG4A Recombinant Rabbit Monoclonal Antibody (JE32-31) 100 &mu;L;

missing translation for 'onlineSavingsMsg'
Learn More
Learn More
Invitrogen™ ATG4A Recombinant Rabbit Monoclonal Antibody (JE32-31)


Rabbit Recombinant Monoclonal Antibody
Brand: Invitrogen™ MA544797
This item is not returnable.
View return policy
Description
ATG4A Recombinant Monoclonal Antibody for Western Blot, ICC/IF, IHC (P), Flow
Autophagy is the process by which endogenous proteins and damaged organelles are destroyed intracellularly. Autophagy is postulated to be essential for cell homeostasis and cell remodeling during differentiation, metamorphosis, non-apoptotic cell death, and aging. Reduced levels of autophagy have been described in some malignant tumors, and a role for autophagy in controlling the unregulated cell growth linked to cancer has been proposed. This gene encodes a member of the autophagin protein family. The encoded protein is also designated as a member of the C-54 family of cysteine proteases. Transcript variants that encode distinct isoforms have been identified.
Specifications
| ATG4A | |
| Recombinant Monoclonal | |
| 1 mg/mL | |
| TBS with 0.05% BSA, 40% glycerol and 0.05% sodium azide; pH 7.4 | |
| Q8C9S8, Q8WYN0 | |
| ATG4A | |
| Synthetic peptide within human ATG4A aa 1-50/398. | |
| 100 μL | |
| Primary | |
| Human, Mouse, Rat | |
| Antibody | |
| IgG |
| Flow Cytometry, Immunohistochemistry (Paraffin), Western Blot, Immunocytochemistry | |
| JE32-31 | |
| Unconjugated | |
| ATG4A | |
| AI627006; APG4 (ATG4) autophagy-related homolog A; APG4 autophagy 4 homolog A; APG4A; ATG4 autophagy related 4 homolog A; Atg4a; Atg4al; Atg4al1; AUTL2; AUT-like 2 cysteine endopeptidase; AUT-like 2, cysteine endopeptidase; autophagin 2; autophagin-2; autophagy 4 homolog A; autophagy related 4 homolog A; autophagy related 4A cysteine peptidase; autophagy related 4A, cysteine peptidase; autophagy related 4A, cysteine peptidase-like 1; autophagy-related 4A; autophagy-related cysteine endopeptidase 2; Autophagy-related protein 4 homolog A; AV169859; cysteine protease APG4A; cysteine protease ATG4A; hAPG4A; MGC107179 | |
| Rabbit | |
| Protein A | |
| RUO | |
| 115201, 666468, 678769 | |
| Store at 4°C short term. For long term storage, store at -20°C, avoiding freeze/thaw cycles. | |
| Liquid |
Product Content Correction
Your input is important to us. Please complete this form to provide feedback related to the content on this product.
Product Title
Spot an opportunity for improvement?Share a Content Correction